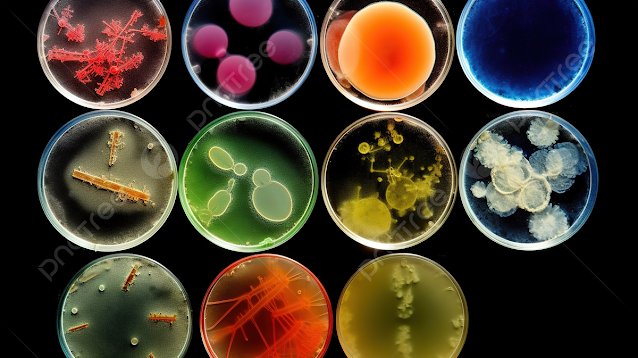

REFORMA TRIBUTÁRIA BRASILEIRA
Reforma Tributária: governo apresenta
lista de produtos da cesta básica; veja
Publicado em 24 de abril de 2024 às 21h05.
O ministro da Fazenda, Fernando Haddad,
apresentou nesta quarta-feira o primeiro e mais amplo projeto de regulamentação
da Reforma Tributária. O projeto apresenta a lista de produtos da cesta básica
nacional, que terão imposto zerado.
Veja a seguir a lista dos produtos com alíquota zero:
Arroz
Leite
fluido pasteurizado ou industrializado, na forma de ultrapasteurizado, leite em
pó, integral, semidesnatado ou desnatado; e fórmulas infantis definidas por
previsão legal específica;
Manteiga
Margarina
Feijões
Raízes
e tubérculos
Cocos
Café
Óleo
de soja
Farinha
de mandioca
Farinha
de trigo
Farinha,
grumos e sêmolas, de milho, e grãos esmagados ou em flocos, de milho,
Açúcar
Massas
Pão
do tipo comum (contendo apenas farinha de cereais, fermento biológico, água e
sal)
Ovos
Produtos
hortícolas, exceto cogumelos e trufas
Frutas
frescas ou refrigeradas e frutas congeladas sem adição de açúcar ou de outros
corantes
Outros
produtos terão redução de 60% na alíquota:
Carnes
bovina, suína, ovina, caprina e de aves e produtos de origem animal (exceto
Foies gras), carne caprina e miudezas comestíveis de ovinos e caprinos
Peixes
e carnes de peixes (exceto salmonídeos, atuns; bacalhaus, hadoque, saithe e
ovas e outros subprodutos)
Crustáceos
(exceto lagostas e lagostim) e moluscos
Leite
fermentado, bebidas e compostos lácteos;
Queijos
tipo mozarela, minas, prato, queijo de coalho, ricota, requeijão, queijo
provolone, queijo parmesão, queijo fresco não maturado e queijo do reino;
Mel
natural
Mate
Farinha,
grumos e sêmolas, de cerais grãos esmagados ou em flocos, de cereais, e amido
de milho do código
Tapioca
e seus sucedâneos
Óleos
vegetais e óleo de canola
Massas
alimentícias
Sal
de mesa iodado
Sucos
naturais de fruta ou de produtos hortícolas sem adição de açúcar
Polpas
de frutas sem adição de açúcar ou de outros edulcorantes e sem conservantes
Reforma Tributária
Após décadas de discussões, o Congresso
Nacional aprovou a Reforma Tributária no fim do ano passado. O texto atualiza o sistema tributário
brasileiro.
Veja também
Reforma tributária: leia íntegra da
proposta de regulamentação do governo
Pacheco adia
sessão sobre vetos, governo evita derrotas, e Lira demonstra insatisfação
Reforma
tributária: nova alíquota será entre 25,7% e 27,3%, diz Appy.
Pela Emenda Constitucional, cinco tributos
sobre consumo em vigor hoje serão unidos e substituídos por um Imposto sobre
Valor Agregado (IVA). Após a cobrança e
pagamento pelos contribuintes, esse imposto vai se dividir em dois, um
gerenciado pela União, e outro com gestão compartilhada entre estados e
municípios:
Contribuição sobre Bens e Serviços (CBS): com gestão federal, vai
unificar IPI, PIS e Cofins;
Imposto
sobre Bens e Serviços (IBS): com gestão
compartilhada estados e municípios, unificará ICMS
(estadual) e ISS (municipal).
O imposto vai incidir no momento de cada
compra, a chamada cobrança no destino. Hoje os impostos recaem sobre os
produtos na origem, ou seja, desde a fabricação até a venda final. Essa
modalidade leva a um acúmulo das taxas ao longo da cadeia produtiva, deixando o
produto mais caro. No modelo do IVA, os impostos não são cumulativos ao longo
da cadeia de produção de um item.
O valor padrão do IVA ainda será definido
e deve ser descoberto apenas um ano antes de cada etapa de transição. Mas uma
estimativa inicial pode ser publicada pelo governo ainda neste ano. De acordo
com a última previsão do ministro da Fazenda, Fernando Haddad, o IVA poderia
chegar a 27,5%.
A transição entre sistemas começa em 2026,
com a cobrança de apenas 1% de IVA. O valor vai aumentando ao longo dos anos
seguintes, até chegar em 2033, quando todos os impostos sobre consumo serão
extintos, e sobrará apenas o IVA. O valor cheio será definido em resolução do
Senado Federal, que também determinará qual parcela cabe ao CBS e qual será de
IBS.
Comentário:
Será que essa Reforma Tributária vai
vingar? Se realmente zerar e reduzir as
alíquotas em 60% para toda população no mercado
nacional vai baixar os preços no comércio e não vai haver mais inflação. Só
virá a inflação se os combustíveis fósseis aumentarem os preços e a taxa da
Selic também. Com essas reformas tributárias em vigor de preferência o mais
breve possível neste ano (2024) para aumentar o
valor dos salários de fome do trabalhador brasileiro e do serviço público e
tirar essa população da fome e da miséria social.
Esse negócio quando todos os impostos
sobre consumo serão extintos, e sobrará apenas o IVA, em compensação o IVA que
já está hoje o mais caro do mundo vai ficar ainda mais caro em 2033. O governo
não dá murro em ponta de faca, está preparando algum golpe que garanta estas
benesses tributárias para o povo brasileiro numa forma de compensação, em breve
num futuro próximo. Alguém vai sair chamuscado nessa Reforma Tributária se não
for o povo será as empresas privadas (agronegócio,
indústrias e comércio). Tudo que o governo faz é para ganhar ou
prejudicar alguém ou alguma coisa, o governo nunca perde, só ganha. Essa
Reforma Tributária está boa demais para ser verdade, vamos esperar o resultado
de tudo isso! O povo não aguenta mais tantos impostos embutidos nas mercadorias
desde a fonte ao consumidor, os impostos também sufocam e deixam o povo na
inadimplência.
Isto está me cheirando a intervenção do FMI na sua economia austera que não leva a nada e sim, ao sacrifício do povo e do país alienado pelos grilhões dos banqueiros nacionais e internacionais esmagando o poder aquisitivo do trabalhador e das empresas nacionais através das falências pelos juros altíssimos. O país é rico e tem como tirar de outras fontes principalmente dos sonegadores que estão sugando o sangue do país. Temos o ouro e outras riquezas minerais que podem ser taxadas e cobrir os déficits do Brasil. Temos os ricos que podem ser taxados.
Ernani Serra
https://g1.globo.com/jornal-da-globo/
https://www.youtube.com/watch?v=U28ET12V3Wg
https://averdadenainternet.blogspot.com/search?q=Reforma+Tribut%C3%A1ria
https://g1.globo.com/economia/noticia/2024/04/24/reforma-tributaria-governo-detalha-propostas-para-cesta-basica-cashback-e-imposto-do-pecado.ghtml
Pensamento: O
tributo fiscal quando exagerado nada mais é do que uma pena de morte as
finanças do capital e do poder aquisitivo do trabalhador em benefício dos
políticos que não usam os tributos em prol da nação ou do país.
Ernani Serra